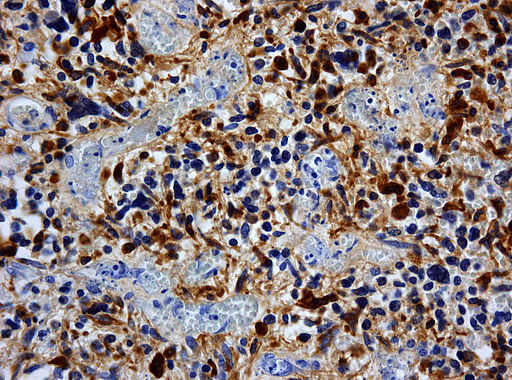
Image of glioblastoma GFAP.

With abundant experience in antibody development, Creative Biolabs offers high-quality IVD (in vitro diagnostic) antibody development services targeting different markers of cancers. Here, we introduce the glial fibrillary acidic protein (GFAP) as a diagnostic marker of glioma and germ cell cancer.
Glial Fibrillary Acidic Protein (GFAP)
Glial fibrillary acidic protein (GFAP) is encoded by the GFAP gene in humans. GFAP is an intermediate filament (IF) protein which is expressed by numerous cell types of the central nervous system (CNS) including ependymal and astrocytes cells. It has also been found that GFAP is expressed in glomerular and tubular fibroblasts of rat kidney Leydig cells, human osteocytes, human keratinocytes and chondrocytes taken from rat hamsters and human testes, and stellate cells of rat pancreas and liver. GFAP is a type III IF protein which maps to 17q21 in humans. GFAP is closely related to its non-epithelial members, including peripherin, desmin, and vimentin, all of which are involved in the structure and function of the cytoskeleton. There are multiple disorders associated with improper GFAP regulation, and injury can cause glial cells to react in detrimental ways.
Fig.1 Glioblastoma GFAP. Distributed under CC BY-SA 3.0, from Wiki, without modification.
Fig.1 Glioblastoma GFAP. Distributed under CC BY-SA 3.0, from Wiki, without modification.
GFAP Marker of Glioma
The serum markers of malignant cerebral astrocytoma can improve the differential diagnosis and clinical treatment of brain tumor patients. In a study, serum GFAP levels were determined using a commercially available ELISA test and were detectable in 40 out of the 50 GBM patients. The levels were significantly elevated compared to the non-GBM tumor patients and healthy controls. Non-GBM tumor patients and all healthy subjects showed zero serum GFAP levels. Therefore, serum GFAP constitutes a great diagnostic biomarker for GBM.
GFAP Marker of Germ Cell Cancer
Teratoma is a type of germ cell cancer that belongs to the nongerminomatous, which can be classified by mature teratoma, dermoid cyst, immature teratoma and teratoma with malignant transformation. Immature teratoma is a rare type of malignant germ cell cancer. Just like mature teratoma, it contains several different types of tissue like hair, muscle, bone. However, unlike mature teratoma, immature teratoma contains immature neural elements, including, oligodendroglia and astrocytes. It has been reported that the staining of GFAP was positive in immature teratoma. Taken together, GFAP can be used to distinguish the different types of teratoma.
IVD Antibody Development Service Targeting GFAP Marker
IVD antibodies are extensively used in immunodiagnostic kits for disease screening and therapeutic monitoring. Through our role as a leading antibody service provider, Creative Biolabs is well-positioned to develop novel GFAP-specific antibodies for diagnostic uses. With our versatile IVD platform, we also offer immunoassay development services from scratch to commercial IVD kits. We can start with antigen sequences or available antibody pairs.
Creative Biolabs has focused on antibody discovery for years. We are therefore confident in offering the best quality services and finest results to our customers. If you are interested in our IVD antibody discovery services, please contact us for more details.
For Research Use Only.